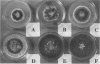

Abstract
The effect of 12 surfactants on aflatoxin production, growth, and conidial germination by the fungus Aspergillus flavus is reported. Five nonionic surfactants, Triton X-100, Tergitol NP-7, Tergitol NP-10, polyoxyethylene (POE) 10 lauryl ether, and Latron AG-98, reduced aflatoxin production by 96 to 99% at 1% (wt/vol). Colony growth was restricted by the five nonionic surfactants at this concentration. Aflatoxin production was inhibited 31 to 53% by lower concentrations of Triton X-100 (0.001 to 0.0001%) at which colony growth was not affected. Triton X-301, a POE-derived anionic surfactant, had an effect on colony growth and aflatoxin production similar to that of the five POE-derived nonionic surfactants. Sodium dodecyl sulfate (SDS), an anionic surfactant, and dodecyltrimethylammonium bromide, a cationic surfactant, suppressed conidial germination at 1% (wt/vol). SDS had no effect on aflatoxin production or colony growth at 0.001%. The degree of aflatoxin inhibition by a surfactant appears to be a function of the length of the hydrophobic and hydrophilic chains of POE-derived surfactants.
Full text
PDF




Images in this article
Selected References
These references are in PubMed. This may not be the complete list of references from this article.
- Bennett J. W., Christensen S. B. New perspectives on aflatoxin biosynthesis. Adv Appl Microbiol. 1983;29:53–92. doi: 10.1016/s0065-2164(08)70354-x. [DOI] [PubMed] [Google Scholar]
- Beuchat L. R., De Daza M. S. Evaluation of Chemicals for Restricting Colony Spreading by a Xerophilic Mold, Eurotium amstelodami, on Dichloran-18% Glycerol Agar. Appl Environ Microbiol. 1992 Jun;58(6):2093–2095. doi: 10.1128/aem.58.6.2093-2095.1992. [DOI] [PMC free article] [PubMed] [Google Scholar]
- Bhatnagar D., McCormick S. P., Lee L. S., Hill R. A. Identification of O-methylsterigmatocystin as an aflatoxin B1 and G1 precursor in Aspergillus parasiticus. Appl Environ Microbiol. 1987 May;53(5):1028–1033. doi: 10.1128/aem.53.5.1028-1033.1987. [DOI] [PMC free article] [PubMed] [Google Scholar]
- Buchanan R. L., Hoover D. G., Jones S. B. Caffeine inhibition of aflatoxin production: mode of action. Appl Environ Microbiol. 1983 Nov;46(5):1193–1200. doi: 10.1128/aem.46.5.1193-1200.1983. [DOI] [PMC free article] [PubMed] [Google Scholar]
- Buchanan R. L., Lewis D. F. Caffeine inhibition of aflatoxin synthesis: probable site of action. Appl Environ Microbiol. 1984 Jun;47(6):1216–1220. doi: 10.1128/aem.47.6.1216-1220.1984. [DOI] [PMC free article] [PubMed] [Google Scholar]
- Cleveland T. E., Lax A. R., Lee L. S., Bhatnagar D. Appearance of enzyme activities catalyzing conversion of sterigmatocystin to aflatoxin B1 in late-growth-phase Aspergillus parasiticus cultures. Appl Environ Microbiol. 1987 Jul;53(7):1711–1713. doi: 10.1128/aem.53.7.1711-1713.1987. [DOI] [PMC free article] [PubMed] [Google Scholar]
- Dutton M. F. Enzymes and aflatoxin biosynthesis. Microbiol Rev. 1988 Jun;52(2):274–295. doi: 10.1128/mr.52.2.274-295.1988. [DOI] [PMC free article] [PubMed] [Google Scholar]
- Ellis W. O., Smith J. P., Simpson B. K., Oldham J. H. Aflatoxins in food: occurrence, biosynthesis, effects on organisms, detection, and methods of control. Crit Rev Food Sci Nutr. 1991;30(4):403–439. doi: 10.1080/10408399109527551. [DOI] [PubMed] [Google Scholar]
- Gottlieb D. Limited growth in fungi. Mycologia. 1971 May-Jun;63(3):619–629. [PubMed] [Google Scholar]
- Hsieh D. P. Inhibition of aflatoxin biosynthesis of dichlorvos. J Agric Food Chem. 1973 May-Jun;21(3):468–470. doi: 10.1021/jf60187a035. [DOI] [PubMed] [Google Scholar]
- Joffe A. Z. Aflatoxin produced by 1,626 isolates of Aspergillus flavus from groundnut kernels and soils in Israel. Nature. 1969 Feb 1;221(5179):492–492. doi: 10.1038/221492a0. [DOI] [PubMed] [Google Scholar]
- Kramer V. C., Nickerson K. W., Hamlett N. V., O'Hara C. Prevalence of extreme detergent resistance among the Enterobacteriaceae. Can J Microbiol. 1984 May;30(5):711–713. doi: 10.1139/m84-106. [DOI] [PubMed] [Google Scholar]
- Kurtzman C. P., Horn B. W., Hesseltine C. W. Aspergillus nomius, a new aflatoxin-producing species related to Aspergillus flavus and Aspergillus tamarii. Antonie Van Leeuwenhoek. 1987;53(3):147–158. doi: 10.1007/BF00393843. [DOI] [PubMed] [Google Scholar]
- Parrish F. W., Wiley B. J., Simmons E. G., Long L., Jr Production of aflatoxins and kojic acid by species of Aspergillus and Penicillium. Appl Microbiol. 1966 Jan;14(1):139–139. doi: 10.1128/am.14.1.139-.1966. [DOI] [PMC free article] [PubMed] [Google Scholar]
- Singh R., Hsieh D. P. Aflatoxin biosynthetic pathway: elucidation by using blocked mutants of Aspergillus parasiticus. Arch Biochem Biophys. 1977 Jan 15;178(1):285–292. doi: 10.1016/0003-9861(77)90193-x. [DOI] [PubMed] [Google Scholar]